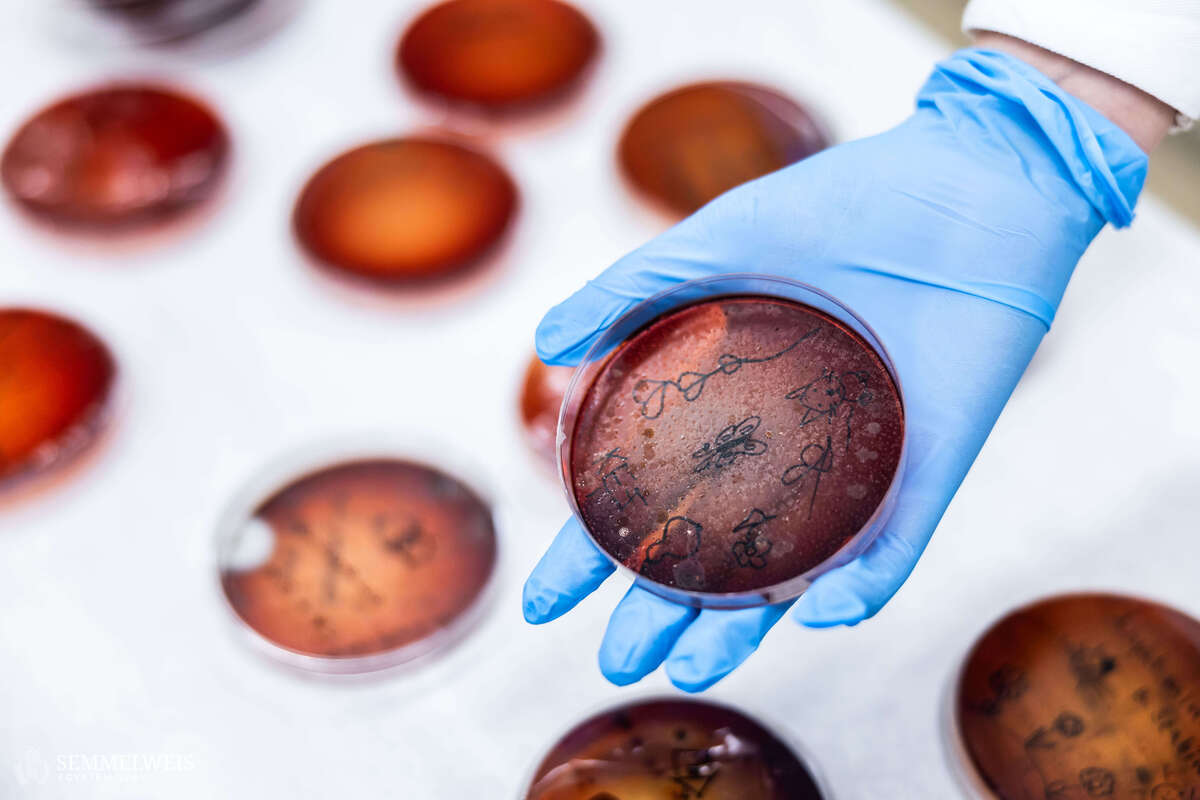

A január végi online nyílt nap után immár harmadik éve személyes kampusztúrát (Campus Tour) is szervezett a Semmelweis Egyetem azoknak a felvételizőknek, akik érdeklődnek az orvos- és egészségtudományi területek iránt.
Az Egészségtudományi Karon (ETK) kiscsoportos hallgatói vezetéssel járhatták végig a középiskolások a kar nevezetes helyeit. Varga Loretta, a Közegészségtudományi Tanszék tanársegéde a kémiai és mikrobiológiai laborban adott bepillantást a dietetikus és a népegészségügyi szakterület iránt érdeklődőknek az itt oktatott tárgyakba. A szülészeti demonstrációs teremben harmadéves szülésznő hallgatók mutatták be, hogyan jutnak el a hallgatók az elméleti oktatástól a gyakorlatokon át a szülések levezetéséig. A kari hallgatói fórumon pedig a felvételivel és a tanulmányokkal kapcsolatos főbb kérdésekre kaphattak válaszokat a felsőbb évesektől az érdeklődők.
Az egyetem mind a hat kara kínált programokat a leendő felvételizőknek. Az Általános Orvostudományi Kar (ÁOK) és a Fogorvostudományi Kar (FOK) iránt érdeklődők számára a fő helyszínek közt szerepelt az Elméleti Orvostudományi Központ (EOK), illetve a Szentkirályi utcai Fogorvostudományi Oktatási Centrum (FOCI). Az Egészségügyi Közszolgálati Kar (EKK) a Nagyvárad téri Elméleti Tömbben (NET) alapképzéséről és az újonnan induló mesterképzéseiről is tartott tájékoztatót. A Pető András Kar (PAK) pedig a Kútvölgyi úti épületében mutatta be a konduktor képzésének gyakorlati helyszíneit.
„Debrecenből érkeztem az Ady Endre Gimnáziumból, emelt nyelvi szakra járunk” – mondta el egyik résztvevő lány. Hozzátette, azután kezdte érdekelni a szakterület, hogy a 9. évfolyamon megismerkedhetett a biológia és a kémia tárgyakkal. „Rájöttem, szeretném segíteni az embereket, orvos szeretnék lenni. A szüleim teljesen más területen dolgoznak, technikumot végeztek, de támogatnak az elhatározásomban. Most 11. évfolyamra járok, szeretnék jövőre jelentkezni biológia országos tanulmányi versenyre, ami plusz pontot is hozhat a felvételihez” – tette hozzá.
„2017-ben érettségiztem, sajnos akkor egymás után kétszer nem sikerült az orvosi felvételi” – mondta el Kitti. Ezután képalkotó diagnosztikát tanult szakképzésben, és klinikai kutatásban kezdett el dolgozni. „Azóta is hiánynak érzem a szakmai továbblépéshez, hogy nem orvosként vehetek részt ezekben a munkákban, ezért úgy döntöttem, 29 évesen újra megpróbálom. Ezúttal bízom benne, hogy sikerülni fog, nagyon szeretném és elszánt vagyok erre” – hangsúlyozta.
A Gyógyszerésztudományi Kar (GYTK) Hőgyes Endre utcai épületében a leglátványosabbak a laborgyakorlatok helyszínei voltak, ahol gyakorlatvezető tanárok adtak bepillantást az összetett munkafolyamatokba. Dr. Mazákné Kraszni Márta egyetemi docens a Gyógyszerészi Kémiai Intézetben egyebek mellett a műszeres hallgatói labor műszereit mutatta be. A szomszédos épületben a gyógynövény- és drogismeret tárgy oktatója hívta fel a figyelmet a tanulmányokban a növényismeret fontosságára: a gyógyszertárakban előforduló hatóanyagoknak mintegy fele a növényekből származik, és a másik felét teszik ki a szintetikus vegyületek. A látogatás látványos részei közé tartozott a tangyógyszertár bemutatása. Az üzemi tanlaboratóriumban kiemelték, a mai gyógyászatban már szerepet kap a személyre szabott gyógyszerelés, és bemutattak egy erre alkalmas 3D gyógyszernyomtatót is, de láthattak vattacukorszerű nanoszálakat előállító berendezést, és a hagyományos tabletta préselését is bemutatták a felvételire készülő középiskolásoknak.
„Nagyjából egy éve kezdtek el érdekelni a gyógyszerészettel kapcsolatos területek” – mondta el Zalán a GYTK-n tett látogatása során. „A budapesti Petrik Lajos vegyipari technikumban tanulok, ahol erős kémiai alapokat adnak, leginkább ez az a terület, amiben magabiztos vagyok. A biológiában még van mit behoznom, de remélem, az is sikerülni fog” – tette hozzá. A csoportból Alexa elmondta, hogy Ceglédről érkezett és kiskora óta gyógyszerész szeretne lenni, leginkább az emberek segítése motiválja és az ipari fejlesztések területén képzeli el a jövőjét.
„Az idei évben először már kétnapos volt a kampusztúra, az előző években ugyanis sokan jelezték, hogy bár szerettek volna eljutni a rendezvényre, hamar beteltek a helyek, így lemaradtak az eseményről” – mondta el honlapunknak Szürös Máté főszervező, a Semmelweis Egyetem HÖK oktatási ügyekért felelős alelnöke. Hozzátette, mintegy harminc HÖK-ös hallgató segítette a szervezést és a 10-20 fős látogatói csoportok vezetését a kétnapos eseményen.
A kampusztúrán a leendő hallgatók testközelből láthatták az épületeket, ahol tanulni fognak, találkozhattak jelenlegi hallgatókkal, oktatókkal, ami szerintem hatalmas motiváció nekik: sokkal közelebb hozza hozzájuk az egyetemet. Az intézménynek is fontos ez az alkalom, mert ezzel bátorítja a jelentkezőket, és még több motivált hallgató választhatja a Semmelweis Egyetemet
– foglalta össze a főszervező.
Szürös Máté szerint a tavalyinál majdnem kétszer több, 1800 főt is meghaladó regisztrációhoz hozzájárulhatott, hogy már az év eleji Educatio oktatási szakkiállításon is hirdették szórólapokkal az eseményt. Továbbá úgy értesültek, hogy az előző évek rendezvényének híre elterjedt a középiskolások között, ami miatt szívesen jöttek most is a diákok a programra. Közölték, a karok közötti látogatói eloszlás tükrözte a karok létszámát: legtöbben, 700 körül az ÁOK-ra látogattak el, majdnem 500-an az ETK-ra, és 327-en a FOK-ra regisztráltak. Amint a szervezők összefoglalták: az idei kampusztúra eredményesen zárult, és jövőre is folytatják az eseményt.
Tasnádi Róbert
Fotó: Barta Bálint; Zellei Boglárka – Semmelweis Egyetem
A cikket a Semmelweis Egyetem Kommunikációs Igazgatósága tette közzé.